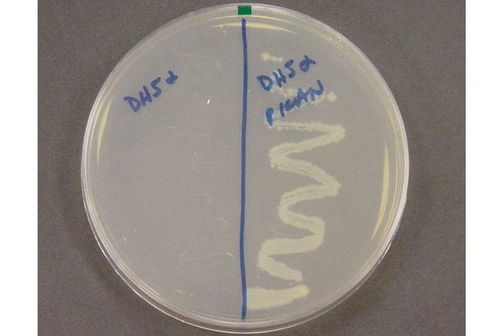

Antibiotic resistance
Some plasmids can make their host bacterium resistant to an antibiotic. In this image, two halves of an agar plate containing the antibiotic kanamycin have been spread with the same strain of E.coli. The bacteria spread on the right-hand side of the plate contain a plasmid that confers resistance to kanamycin, so they can grow colonies even when it is present. On the left-hand side of the plate, the bacteria lack the kanamycin resistance plasmid and have been unable to grow.
Metadata
- Published:
- 25 March 2014
- Copyright:
-
Dr Stephanie Dellis, Molecular Biology Lab at the College of Charleston

